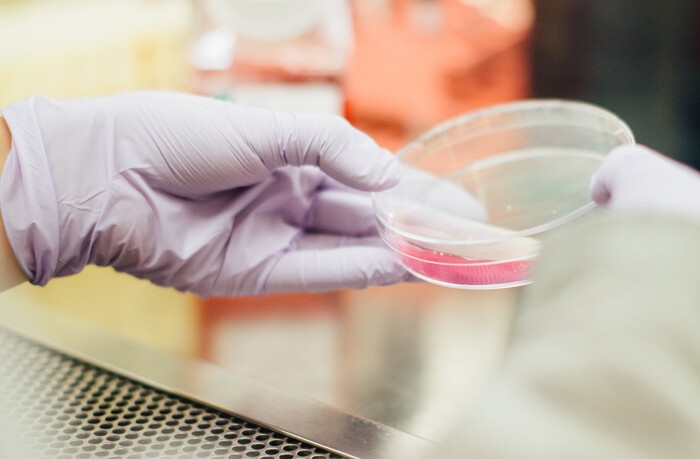

Материалы versus инфекции: какие новые решения для защиты от бактерий создали учёные?
Чтобы победить бактерии, устойчивые к антибиотикам, российские учёные разрабатывают материалы нового поколения, которые становятся надёжным щитом против инфекций. О последних достижениях науки для антимикробной защиты рассказывает директор центра «Неорганические наноматериалы» НИТУ МИСИС, д.ф.-м.н. Дмитрий Штанский.
По данным крупнейшей международной базы научных публикаций Scopus, только в 2025 году по тематике антибактериальной активности опубликовано свыше 23 тысяч статей. Во многих из них речь идёт не о поиске «универсального антибиотика», а о принципиально иной стратегии – поверхностной функционализации медицинских изделий, чтобы они сами по себе были активными участниками борьбы с патогенами. Такой подход к антимикробной защите подходит, к примеру, для ортопедических и дентальных имплантатов, урологических катетеров, раневых повязок, масок для дыхания, фильтров для контура аппарата искусственной вентиляции легких, пищевой упаковки, а также для формы медицинского персонала.
Учёные создают всё больше сложных наноматериалов с заданными свойствами, получая более сильный и управляемый антибактериальный эффект. Совершенствуют способы поверхностной обработки, меняют морфологию и топографию их поверхности и, наносят многофункциональные бактерицидные покрытия. Создают гидрогели нового поколения – мягкие материалы, которые помогают тканям заживать и при этом защищают рану от инфекции. Активно развиваются такие подходы, как высвобождение бактерицидных ионов металлов (серебра, меди и цинка), контролируемая доставка лекарственных веществ, подавление формирования микробных биоплёнок и контактное разрушение бактериальной клетки за счёт особенностей поверхности. Среди наиболее перспективных решений – фотокаталитические системы на основе оксидов титана, цинка и меди, а также модифицированные наноструктуры, способные эффективно генерировать активные формы кислорода. Такие высокореакционные радикалы повреждают клеточную стенку бактерий и запускают в них разрушительные окислительные процессы. Отдельное направление – создание гибридных покрытий, сочетающих сразу несколько механизмов действия антибактериальной защиты, так как комплексный подход снижает вероятность, что бактерии адаптируются к одному конкретному фактору. При этом учёным важно контролировать не только эффективность антимикробного эффекта, но и его управляемость.
Одна из неочевидных проблем при масштабировании подобных разработок заключается в разнящихся получаемых результатах. Это объясняется сложностью биологических процессов, ведь на активность антибактериальной защиты влияет не только её выверенный механизм действия, но и условия среды: механические нагрузки, иммунный ответ организма, присутствие смешанных микробных сообществ. Поэтому параллельно с разработкой новых материалов идёт пересмотр подходов к их тестированию.
В целом разработка антибактериальных материалов всё больше смещается от метода проб и ошибок к осознанному проектированию медицинских изделий с заранее заданными свойствами. Сейчас в центре внимания учёных – многофункциональные и адаптивные системы, способные реагировать на изменения среды и работать локально там, где возникает очаг инфекции.
Следующий рубеж исследований антимикробной защиты находится на пересечении микробиологии, инженерии поверхностей и машинного обучения: с помощью компьютерного моделирования учёные смогут прогнозировать эффективность материалов ещё до их синтеза, ускоряя путь от лабораторных экспериментов к практическому применению в условиях растущей устойчивости бактерий.
Более подробно с исследованиями антимикробных биоматериалов можно ознакомиться в обзоре, опубликованном в журнале «Успехи химии» (Q1).